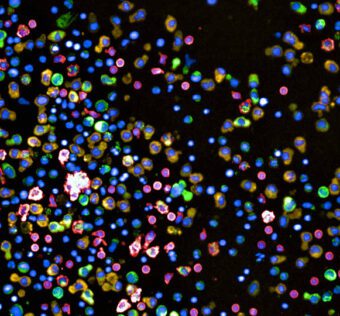

Sources
 Roundup: New AI tools predict Parkinson’s onset, heart attack risk after surgery and more briefs
MobiHealthNews - (Friday May 12, 2023) ML tool predicts Parkinson’s onsetA research team from the University of New South Wales, together with their collaborators from Boston University, has come up with an AI tool that could be potentially used to…  Lululab launching AI beauty research centre with Yonsei Cancer Center
Healthcare IT news - (Friday May 12, 2023) South Korean AI beauty service startup Lululab has tied up with Yonsei Cancer Center’s Scar Laser and Plastic Surgery Center to take their research partnership on the use of AI to treat skin diseases… |
 FWA Is Increasing. Healthcare Costs Are Spiraling. Now There’s A New Generation Of AI Technology To Take Back Control
HIT Consultant - (Friday May 12, 2023) Theja Birur, Chief Technology Officer & Founder, 4L Data IntelligenceIn 2020, the Department of Justice estimated that fraudulent, wasteful, and abusive (FWA) billing practices account for more than $100 billion of the nation’s healthcare… High-Throughput Testing of Hundreds of Anti-Cancer Drug Combinations |
Medgadget - (Friday May 12, 2023) Researchers at ETH Zurich in Switzerland have developed a high-throughput screening method for anti-cancer drugs that they have called “pharmascopy”. To date, the researchers have tested the system with multiple myeloma samples, a cancer… |
 Brain Decoder Spells Out Thoughts |
Medgadget - (Friday May 12, 2023) Researcher scientists at the University of Texas at Austin have developed a brain decoding technology that combines an fMRI scanner and artificial intelligence, similar to well-known AI systems such ChatGPT or Bard. The technology…  News 5/12/23 – HIStalk
HIStalk - (Friday May 12, 2023) Top News London-based, digital-first primary care operator Babylon Health will take itself private, 18 months after it went public in a SPAC merger that the CEO says was a “big mistake.” |
 Analysis: Sharecare Poised for Re-Acceleration, 1Q Results
HIT Consultant - (Thursday May 11, 2023) What You Should Know:On 5/10/23, BMO, Sharecare (SHCR) delivered what appear to be, good 1Q results. Revenue of $116.3M + 15.5% y/y, compares to BTIG / FactSet consensus of $111M / $110.9M and adjusted…  EPtalk by Dr. Jayne 5/11/23 – HIStalk
HIStalk - (Thursday May 11, 2023) |
 FDA’s Landmark Guidance on Decentralized Clinical Trials (DCTs) Signals a New Era of Patient-Centered Research
MedCity News - (Thursday May 11, 2023) The FDA’s new draft guidance on Decentralized Clinical Trials (DCTs) is a landmark moment for the industry, emphasizing the importance of virtual trials for improving patient access to groundbreaking research while providing recommendations on…  What’s New in Telehealth Reimbursements for 2023?
HealthTech Magazine - (Thursday May 11, 2023) Updates for Telehealth Reimbursement in 2023Here is how the passing of the Consolidated Appropriations Act of 2023 will impact healthcare organizations: |




